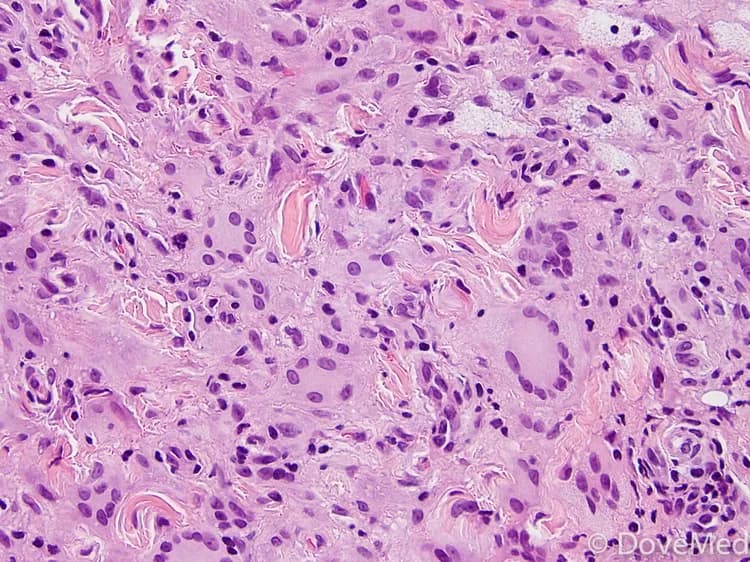

What are the other Names for this Condition? (Also known as/Synonyms)
- GA (Granuloma Annulare)
What is Granuloma Annulare? (Definition/Background Information)
- Granuloma Annulare (GA) is common skin condition that occurs as a rash of the skin. In this condition, red bumps appear in the shape of a ring on the skin and may become itchy
- It is a chronic condition with the presence of multiple papules that are found on the hands, feet, elbows, and knees of children and young adults. The rashes may appear localized or generalized (all over the body)
- The cause of occurrence of Granuloma Annulare is unknown and no risk factors have been documented, apart from poorly-controlled diabetes
- In most cases, no treatment may be necessary for Granuloma Annulare and the skin condition may resolve on its own. The prognosis of the condition is excellent with suitable treatment
Who gets Granuloma Annulare? (Age and Sex Distribution)
- Granuloma Annulare is observed in children, teenagers, and young adults. This condition is thought to be more likely to occur in young adult females (around 30 years of age)
- Both males and females are known to be affected, but females are affected more than males; the male to female ratio is 1:2
- Granuloma Annulare is seen worldwide, and all racial and ethnic groups are susceptible
What are the Risk Factors for Granuloma Annulare? (Predisposing Factors)
- Poorly-controlled diabetes can cause generalized Granuloma Annulare
- Research is currently underway to identify relevant risk factors for Granuloma Annulare
It is important to note that having a risk factor does not mean that one will get the condition. A risk factor increases ones chances of getting a condition compared to an individual without the risk factors. Some risk factors are more important than others.
Also, not having a risk factor does not mean that an individual will not get the condition. It is always important to discuss the effect of risk factors with your healthcare provider.
What are the Causes of Granuloma Annulare? (Etiology)
The cause of Granuloma Annulare formation is unknown, but some researchers believe that it is an immune-mediated condition.
- This condition is typically noted in individuals who are healthy
- A presence of Granuloma Annulare does not indicate increased risk of infections or a dangerously altered immune system
- Research is being performed to understand the relevant causative factors
What are the Signs and Symptoms of Granuloma Annulare?
The signs and symptoms of Granuloma Annulare may include:
- The presence of multiple painless papules or red bumps that appear in the shape of a circle or ring on the skin, which may become itchy
- Some cases show multiple rings of red bumps, while others only have one ring
- These may be commonly present on the hands, feet, elbows, and knees
- Granuloma Annulare can be both localized and generalized in nature. The lesions remain localized (mostly), however they have the potential to spread all over the body
- The skin lesions may be present for months and years (chronic condition), before getting better on their own with or without treatment
- Sometimes, no major signs and symptoms are observed apart from the presence of the skin lesions
How is Granuloma Annulare Diagnosed?
Granuloma Annulare is difficult to diagnose, as it does not show many symptoms. the lesions are often initially unsuccessfully treated with topical antifungal creams because of a superficial resemblance to so-called ringworm infection.
The following tools may be employed towards diagnosing Granuloma Annulare :
- Evaluating the clinical history (physical exam) and a thorough family history
- KOH tests to rule out a fungal infection
- Skin biopsy: A skin biopsy is performed and sent to a laboratory for a pathological examination. The pathologist examines the biopsy under a microscope. After putting together clinical findings, special studies on tissues (if needed) and with microscope findings, the pathologist arrives at a definitive diagnosis
- A differential diagnosis may be used to eliminate other rashes and significant skin conditions and infections such as:
- Lichen planus
- Sarcoidosis
- Fungal infections
- Necrobiosis lipoidica
- Lymphocytic infiltrate of Jessner
Many clinical conditions may have similar signs and symptoms. Your healthcare provider may perform additional tests to rule out other clinical conditions to arrive at a definitive diagnosis.
What are the possible Complications of Granuloma Annulare?
The complications of Granuloma Annulare are usually not very significant, but may include the following:
- Recurrences after the signs and symptoms disappear are very commonly noted
- In some individuals, they may cause cosmetic concerns resulting in stress, since Granuloma Annulare may be a longstanding condition
- Some scarring may occur, although typically the lesions disappear without leaving any marks
How is Granuloma Annulare Treated?
In a majority of cases, no treatment may be necessary for Granuloma Annulare. When required, the treatments may include (especially when there are cosmetic concerns):
- Topical steroid creams and ointments
- Injection of corticosteroids into the individual lesions
- Cosmetic surgery
- Cryotherapy or freezing of the bumps or rings
- Photochemotherapy, PUVA or UVB phototherapy
- Oral steroids
How can Granuloma Annulare be Prevented?
- There are no specific prevention methods associated with Granuloma Annulare
- However, a proper control of diabetes may reduce the risk for the generalized form of Granuloma Annulare
What is the Prognosis of Granuloma Annulare? (Outcomes/Resolutions)
- Granuloma Annulare may resolve by itself (spontaneously) in many cases. However, this may take a long period (may be even up to 2 years); also, there is a 40% chance of recurrence of the condition
- Localized granuloma has shown to respond better to treatment than the generalized form. Localized cases show less frequent relapses as well
Additional and Relevant Useful Information for Granuloma Annulare:
The following DoveMed website link is a useful resource for additional information:
Related Articles
Test Your Knowledge
Asked by users
Related Centers
Related Specialties
Related Physicians
Related Procedures
Related Resources
Join DoveHubs
and connect with fellow professionals

0 Comments
Please log in to post a comment.